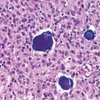

Que hormona se produce en la pineal?
Melatonina
Cual es la función de la melatonina?
Regular los ciclos de sueño vigilia
La pineal es la única estructura del sistema endocrino con calcificaciones (cuerpos amilaces)
Verdadero o Falso
Verdadero
Células que secretan la melatonina
Pinealocitos
Estructura bilobulada del sistema endocrino
Hipófisis
Estructura característica del la glándula pineal
Calcificaciones
Por que la glándula pineal también es conocida como tercer ojo?
Los tumores de glándula pineal tienen manifestaciones en el quiasma óptico por su proximidad
Hormonas que se almacenan en la neurohipófisis
Hormona antidiurética (vasopresina)
Oxitocina
Cuales son las funciones de la neurohipófisis?
Almacenamiento y secreción
Cual es la función de la adenohipófisis?
Almacenamiento , secreción y producción
Tipos de células que nos encontramos en la adenohipófisis?
Acidófilas: Somatotrofas y prolactotrofas
Basofilas: Corticotrofas, tirotrofas y gonadotrofas
Hormonas producidas por células acidófilas
Somatotrofas (hormona de crecimiento)
Lactotrofas (prolactina)
Hormonas producidas por células basófilas?
Corticotropinas (ACTH)
Tirotropinas (TSH)
Gonadotropinas (FSH y LH)
En que estructura se almacenan las hormonas en la hipófisis posterior?
Cuerpos de Herring
núcleos del hipotálamo que producirán las hormonas que se almacenan el la adenohipófisis?
Supraóptico y paraventricular
Núcleo productor de vasopresina ADH (antidiurética)
Supraóptico
Núcleo productor de Oxitocina
Paraventricular
Que estructuras tenemos en la parte media de la hipófisis?
Coloide
Quistes de Rathke
Células basófilas (POMC)
3 tipos de celulas en la adenohipófisis
Acidófilas: rosas
Basófilas: Moradas
Cromófobas: Grises
La nuerohipófisis es________en comparación con la adenohipófisis
Poco celular
Epitelio de la tiroides
Cubico siemple
Parénquima de la tiroides
Folículos tiroideos
Estroma de la tiroides
Tejido conectivo y vasos
Que hormona producen las células parafoliculares?
Calcitonina